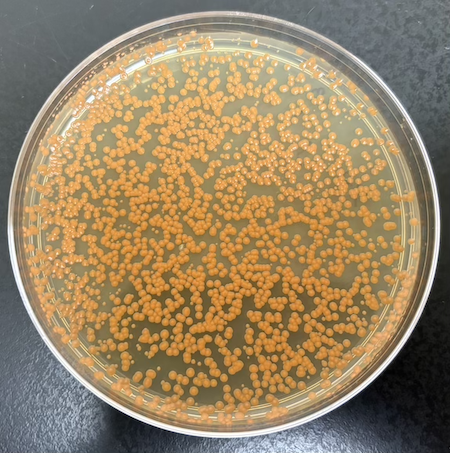

Mansi Srivastava
BISI-MOCB PhD student. Mansi is developing genetic tools to access different Gram-positive bacteria, so that she can investigate the antitermination of secondary metabolite pathways.
John Labella
BISI-MOCB PhD student. John is investigating the processive antitermination mechanisms for secondary metabolite and biofilm operons.
Thao Nguyen Phuong Tran
Biochemistry PhD student. Thao is investigating the structure and function of processive antitermination factors.
Conor Jenkins
Biochemistry PhD student. Conor is using proteomics and metabolomics analyses to investigate the biology of “small RNAs”
Colleen Johnston
Undergraduate researcher studying antitermination in Gram-positive bacteria!
Swathi Sevugan
Undergraduate biochemistry researcher working on transcription elongation proteins!
Jennifer Owen
Undergraduate researcher using flow cytometry to look at genetic reporters!
Wade Winkler
Professor, Department of Cell Biology and Molecular Genetics
Bacillus subtilis
Our primary model system
Rossellomorea vietnamensis
We investigate stuff with it.